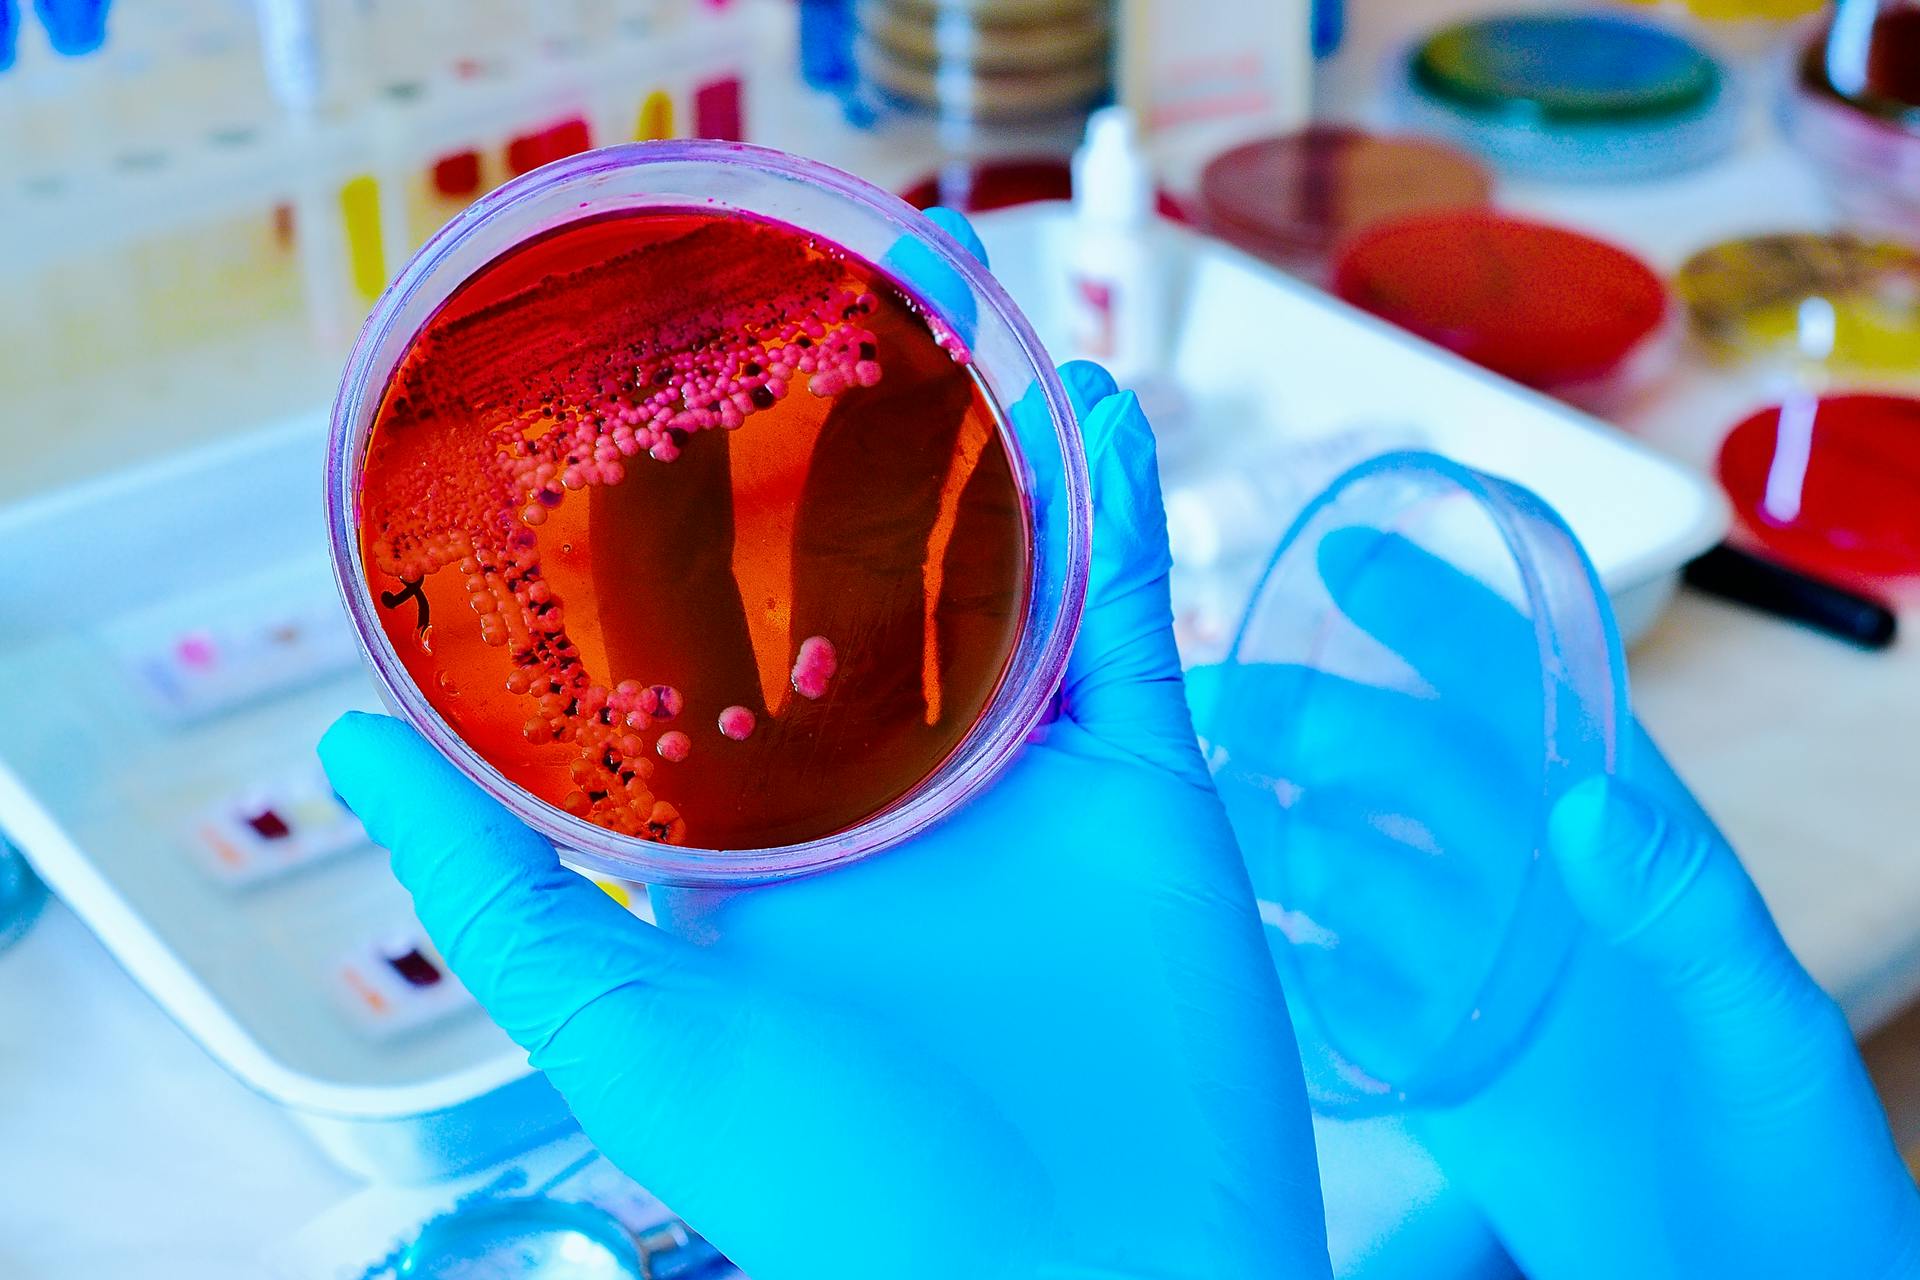
677eb8af2089a2816d957d04 Dreamstime Xl 131289960

Analyzing visible light disinfection in practice
Visible light disinfection technology is being adopted by major luminaire manufacturers for everything from hospital operating theatres to residential kitchens, but the open question for lighting designers is whether it is effective, and under what conditions. More important, what guidelines should be applied to ensure that a given visible light disinfection installation will be effective?
A prior article introduced the history and theory of visible light disinfection (VLD). This article builds on the theory to examine the design parameters of VLD luminaires and the irradiance and daily exposure needed to manage various microbial species in whole-room applications.
Spectral interactions
To date, many studies have focused on narrow spectral bands generated by quasimonochromatic LEDs. One study examined the combination of 405-nm blue light as an antibacterial agent and 880-nm near-infrared radiation as a means of tissue repair, but found that the 880-nm radiation by itself promoted bacterial growth. Another study used an array of phosphor-coated white LEDs with both 405-nm and 450-nm peak wavelengths, with an estimated 6500K CCT, to inactivate SARS-CoV-2 viruses1. However, researchers acknowledged that the growth medium for the infected cells contained fetal bovine serum, which may have contributed to the virus inactivation.
Still, when exposed to broadband “white” light, Enterococcus bacteria (which do not have endogenous polyphorins) are resistant to blue light but are also sensitive to near- and mid-IR radiation2. Trichophyton rubrum fungi are sensitive to green light. The higher dose requirements may preclude these longer wavelengths from practical whole-room visible light disinfection, but more research is required.
Pulsed blue light
Several in vitro studies have investigated the effect of pulsed blue light on VLD efficacy. One study found that when exposing MRSA bacteria to 116 mW/cm2 of 405-nm radiation, varying the pulse-width duty cycle from 25 to 100% had little effect on the dose required to achieve the same degree of inactivation. The pulse-width modulation (PWM) frequency was varied from 100 Hz to 10 kHz, with 1,000 Hz showing the best performance, and with 35% energy savings for a 50% duty factor. Study authors speculated that the cell porphyrins become saturated with continuous exposure, and that the off period of each cycle enables the absorbed light to generate reactive oxygen species (ROS) with fewer photons being absorbed unnecessarily.
Finally, another study demonstrated that pulsed blue with wavelengths ranging from 405 nm to 450 nm inactivated several strains of human coronavirus, but the efficacy varied by strain3. Researchers found the antiviral effect was more pronounced at higher than lower irradiances.
Hospital settings
Most VLD studies have been in vitro experiments performed in laboratories, which is necessary to isolate species and strains, and to control or eliminate the influence of environmental conditions.
Investigating VLD efficacy in vivo under real-world conditions is more difficult, even in hospital settings such as operating theaters and inpatient rooms. Two studies reported on the use of two ceiling-mounted, 405-nm LED arrays in burn unit isolation rooms4,5 with a floor area of approximately 10 m2. The authors wrote that irradiance levels “were set, on the basis of extensive laboratory experimentation, to be sufficient to cause significant inactivation of exposed bacteria within the room environment.” The remainder of the papers were sufficiently detailed, but the lack of irradiance information makes the experiments irreproducible.
Fortunately, another study later described the luminaire used in these studies as “a ceiling-mounted LED array which delivers low-irradiance 405-nm light (irradiance, 0.1 to 0.5 mW/cm2) continuously to decontaminate surface in hospital operating theaters6.”
Bache et al.5 reported that from more than 1,000 environmental samples taken from inpatient isolation rooms and an outpatient clinic, there was a significant reduction in the average number of bacterial colonies (27 to 75%) following LED array use with 14-hour daily exposures. If we assume an average of 50% (0.70 log10) reduction, it would require 20 hours of exposure to achieve 90% reduction. Further assuming an average irradiance of 0.3 mW/cm2, the dose would be 21.6 J/cm2.
The study involved Staphylococcus aureus and referenced earlier research showing that the required dose for 90% reduction was 9.8 J/cm2. While noting that the burn unit rooms had HEPA filters and underwent daily terminal cleaning to minimize the risk of hospital-acquired wound infections, the results were commensurate with what would be expected from laboratory dose requirements.
Bache et al.7 continued these studies within the burn unit isolation rooms, finding that there was no correlation between irradiance levels and bacterial inactivation over a range of 0.0023 mW/cm2 to 0.231 mW/cm2. However, scientists found a strong correlation between exposure time (i.e., dose) and bacterial inactivation. The authors attributed this to the bacteria being suspended in air almost indefinitely, which would expose them to higher spherical irradiance levels near the LED arrays due to air movement within the room. Related to this, Dougall et al.8 reported that, in aerosol form, Staphylococcus epidermidis was three to four times more susceptible to 405-nm irradiation than when in liquids or on surfaces. This is similar to the susceptibility of most pathogens to UV-C radiation.
This highlights perhaps the most significant difference between ultraviolet radiation and visible light for whole-room disinfection. In most applications, UV-C radiation is used to disinfect air, so proper air flow is a critical parameter. To date, however, VLD research has focused on surface disinfection. Some studies suggest that visible light may be useful in air disinfection, but there is no conclusive evidence as of yet.
Rutala et al.9 reported a study involving a 12.5-m2 windowless room equipped with two 61×61-cm (2-ft2) “blended-white light” LED luminaires and one 61×122-cm “blue light” LED luminaire. The white-light luminaires provided both disinfection radiation (presumably 405 nm) and “ambient white” light illumination for use in typical clinical applications in an occupied room with an irradiance of 0.12 to 0.16mW/cm2 on the pathogen surface, while the disinfecting “blue light” luminaire provided an irradiance of 0.34 to 0.44 mW/cm2.
Again, without knowing the spectral power distribution of the luminaires, it is difficult to reproduce the experiments reported in the study. Nevertheless, the results shown in Table 1 for 90% reduction are informative. The four pathogens are common infectious bacteria in hospitals, but E. faecalis (responsible for urinary tract infections and meningitis) did not respond to white light, while C. difficile (responsible for a quarter of a million hospital infections per year) did not respond to white or blue light at all.
These results highlight an important issue with VLD: The range of doses required for different species and even strains of pathogens is enormous. Clostridium difficile is a spore-forming bacterium that exists in two states: vegetative and endospore. In its vegetative state, it requires a dose of 13 to 77 J/cm2 for 90% reduction; in its endospore state, the dose ranges from 426 to 736 J/cm2.
The record holder is Aspergillus niger, a common food contaminant that also forms black mold in indoor environments — its spores require an astonishing 23,000 J/cm2 to achieve 90% reduction.
Sunlight
The health benefits of sunlight exposure, or heliotherapy, have been recognized for six millennia. On a clear day with the sun at zenith, the radiant flux in the Soret band (~390 to 420 nm) is about 5 mW/cm2 (and about 0.5 mW/cm2 on an overcast day). Over eight hours, this is about 150 J/cm2. Simply put, direct sunlight is an excellent visible light disinfectant (not to mention the antimicrobial effects of UV-A and UV-B radiation). One study reported that the half-life (70% reduction) of influenza viruses in full direct sunlight is about 150 seconds.
To put this into perspective, 5 mW/cm2 translates into 500W of 405-nm radiant flux for a 10-m2 (108-ft2) room. If direct sunlight is available, it is a far better choice for visible light disinfection than electric lighting.
Whole-room disinfection
Evidence shows that whole-room VLD systems are useful as a supplement to terminal cleaning in hospital settings. This includes both occupied inpatient rooms with continuous illumination and unoccupied spaces, such as operating theaters, where higher blue-light irradiances can be employed. Typical irradiances will be on the order of 0.1 to 0.5 mW/cm2 (1 to 5 W/m2), with typical exposure times of 8 to 14 hours to prevent pathogens from proliferating.
However, whole-room VLD systems have not been proven capable of delivering the irradiances and doses needed to control or eradicate common hospital pathogens such as Clostridium difficile, let alone the common food contaminant Aspergillus niger.
One luminaire manufacturer currently claims that its products are effective against 26 bacteria, yeast, fungi, and viral species. The literature indicates that many of these species may require doses for 90% inactivation that far exceed what practical whole-room VLD systems can provide.
As shown in Table 2, the optical power required to inactivate some pathogens can be unrealistic. Assuming a radiant efficiency of 70%, an electrical load from 900W to over 100 kW would be required to control an Aspergillus niger colony in a small room!
Some of these maximum doses are related to specific laboratory conditions that may not reflect those of whole-room applications. Nevertheless, marketing claims should be viewed with a critical eye.
Conclusions
Professional lighting designers would prefer recommendations such as “the visible light irradiance on the workplane shall be between 0.1 and 0.5 J/cm2, and the daily radiant dose shall be no less than 12 hours.” Unfortunately, the reality is that we live in a dirty world with innumerable species and strains of pathogens that visible light cannot inactivate by even 90% without impractical irradiance levels and radiant doses.
A range of peer-reviewed studies have shown that visible light has antimicrobial properties under carefully controlled laboratory conditions and (to a lesser extent) in hospital settings that were already designed to minimize the prevalence of pathogens through HEPA-filtered air and daily terminal cleaning. However, they also demonstrate that their results cannot be extrapolated to predict the performance of VLD systems in whole rooms, nor do they provide evidentiary support for lighting design guidelines.
In summary, VLD technology may be useful in some applications, but it is by no means a panacea. When designing or specifying a disinfection system, both the lighting designer and the client will need to thoroughly understand the capabilities and limitations of the technology and agree upon its purpose.
Information statement
All of the statements made in this article are supported by peer-reviewed academic studies. An extended version of this article with 54 references is available from the IES Forum for Illumination Research, Engineering, and Science (FIRES).
REFERENCES
1. R. De Santis et al., “Rapid inactivation of SARS-CoV-2 with LED irradiation of visible spectrum wavelengths,” J. Photochem and Photobio, 8:100082 (2020).
2. P.J. Gwynne and M.P. Gallagher, “Light as a broad-spectrum antimicrobial,” Frontiers in Microbio, 9, Article 119 (2018).
3. C.S. Enwemeka et al., “Pulsed blue light inactivates two strains of human coronavirus,” J. Photochem and Photobio B: Bio, 222:112282 (2021a).
4. M. Maclean et al., “Environmental decontamination of a hospital isolation room using high-intensity narrow-spectrum light,” J. Hospital Infection, 76:247–251 (2010).
5. S.E. Bache et al., “Clinical studies of the high-intensity narrow-spectrum light environmental decontamination system (HINS-light EDS) for continuous disinfection in the burn unit inpatient and outpatient settings,” Burns, 38:68-79 (2012).
6. F.D. Halstead et al., “Violet-blue light arrays at 405 nm exert enhanced antimicrobial activity for disinfection of monomicrobial nosocomial biofilms,” Appl and Environ Microbio, 85(21):1–16 (2019).
7. S.E. Bache et al., “Universal decontamination of hospital surfaces in an occupied inpatient room with a continuous 405 nm light source,” J. Hospital Infection, 98(1):P67–73 (2017).
8. L.R. Dougall et al., “Efficacy of antimicrobial 405 nm blue-light for inactivation of airborne bacteria,” Proc. SPIE 10479, Light-Based Diagnosis and Treatment of Infectious Diseases, 104791G (2018).
9. W.A. Rutala et al., “Antimicrobial activity of a continuous visible light disinfection system,” Infectious Control Hospital Epidem, 39(10):1250–1258 (2018).
10. R.M. Tomb et al., “Review of the comparative susceptibility of microbial species to photoinactivation using 380-480 nm violet-blue light,” Photochem and Photobio, 94(3):445–458 (2018).
Get to know our expert
IAN ASHDOWN, P. Eng. (Ret.), FIES, is a consultant with 40 years’ experience in lighting design, research and development, and software engineering. He is currently senior scientist and president of SunTracker Technologies in Victoria, British Columbia, Canada, where he is developing lighting design software for architectural, horticultural, entertainment, and health applications. Ashdown has presented at industry events and contributed, reviewed, and edited several technical journals and trade publications.
The views and conclusions from this author are not necessarily those of LEDs Magazine.
Extended online version; abridged version published in the October 2022 issue of LEDs Magazine.
For up-to-the-minute LED and SSL updates, follow us on Twitter. You’ll find curated content and commentary, as well as information on industry events, webcasts, and surveys on our LinkedIn page and our Facebook page.
About the Author

Ian Ashdown
President & Owner
Ian Ashdown is a consultant with nearly 40 years' experience in lighting design, research and development, and software engineering. He is chief senior scientist for SunTracker Technologies. He is currently hard at work on several projects involving intelligent lighting controls and real-time dynamic lighting design software.